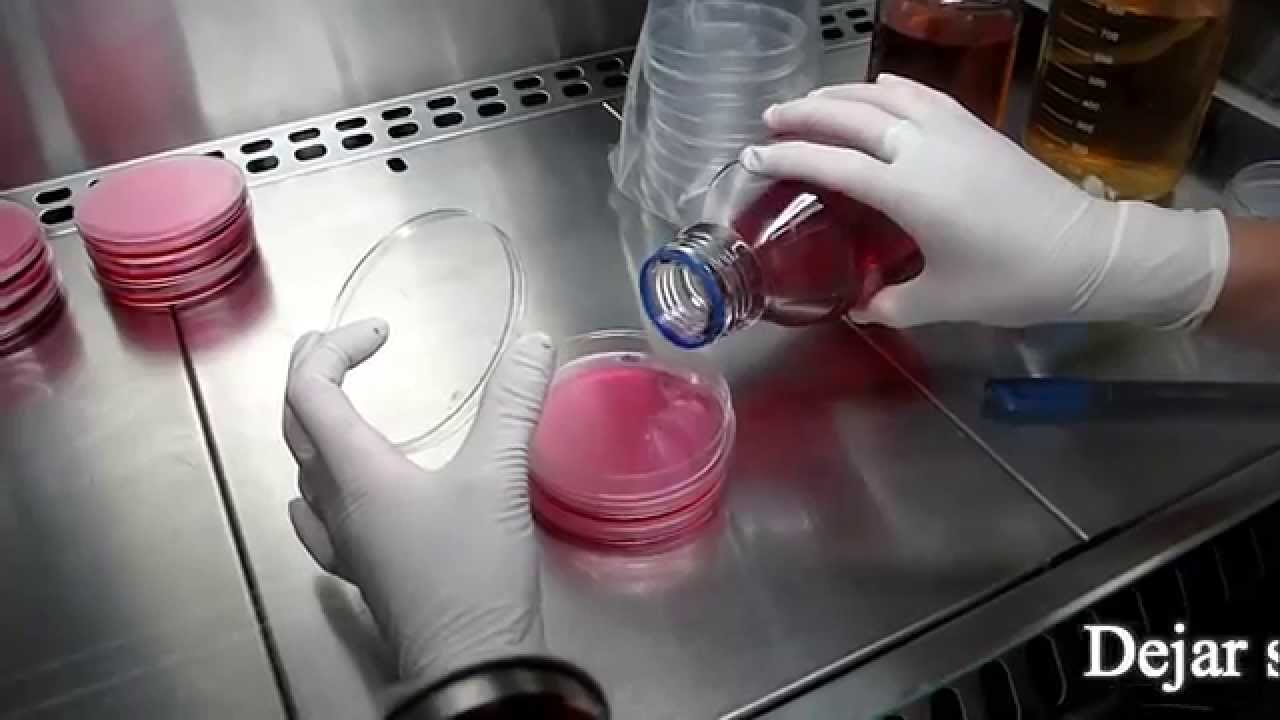
Técnicas básicas de Microbiología: Preparación de Placas de Petri con medio de cultivo.

Web• Las cajas petri sólo había que voltearlas de tal manera que la tapa quedara abajo. • Después doblamos las pipetas y cajas de petri de tal manera que no les entrara el vapor.
Minisplit Mirage Inverter 2 Toneladas, Conoce Minisplit Mirage INVERTER X | 17 SEERS, 9.66 MB, 07:02, 17,773, CESEAA AIRES ACONDICIONADOS, 2022-03-21T00:06:11.000000Z, 9, Aire Minisplit Inverter X 220v Mirage 2 Ton 24 000 B Ahorro | Envío gratis, articulo.mercadolibre.com.mx, 856 x 821, jpeg, minisplit mirage inverter, 20, minisplit-mirage-inverter-2-toneladas, New Topics
WebLa palabra representa el significado de CAJA DE PETRI o cualquier otra palabra es una manera que es normalizada por la población, por medio del contrato. WebSe le conoce como caja o placa de Petri. Esta es un recipiente redondo, bien sea de plástico o cristal, acompañado por una cubierta de igual forma que la placa,. WebLa caja de Petri, también conocida como placa de Petri, fue ideada por este microbiólogo cuando colaboraba con Robert Koch (1843-1910), el médico que recibió el Premio. WebLa Caja Petri o Placa de Petri es un instrumento de laboratorio el cual puede ser de cristal o de plástico. Los hay de diferentes diámetros, los más utilizados en el. WebLa caja o placa de Petri es un recipiente redondo, de cristal , para que se pueda colocar encima y cerrar el recipiente, aunque no de forma hermética. Es parte de. WebLas placas de Petri son un elemento común que se encuentra en los laboratorios de ciencias tanto profesionales como educativos. Desafortunadamente, las. WebUna placa de Petri es una placa cilíndrica poco profunda de vidrio o plástico que los biólogos utilizan para cultivar células. Debe su nombre al bacteriólogo alemán. WebEn una caja Petri se coloca el inoculo y sobre el mismo se vierte el medio de cultivo previamente fundido. Se mezcla 0 ml con agar a sobrefusiÛn y se coloca en una placa.
Nuevo Definición y origen de CAJA DE PETRI - La Voz Silenciosa actualizar
Que es una caja petri tendencias
Veamos Cultivo bacteriano en placa Petri. Divulgación científica (IQOG-CSIC)
Noticias Técnicas básicas de Microbiología: Preparación de Placas de Petri con medio de cultivo.
Reseñas Manejo de caja petri más
Temas manejo de la placa petri Nuevo
Artículos placa de petri o caja de petri actualizado
Asunto Uso de la placa de Petri.
Explicación Que Es Una Caja De Petri del video anterior
¿Quieres colaborar al mantenimiento de este canal? Apóyalo:
paypal.me/DIAZSALADO
----------------------
Te recomiendo este vídeo: EL CAMARADA DON CAMILO de GIOVANNI GUARESCHI
youtu.be/Opb8tRdO8V4
----------------------------
DEFINICIÓN DE CAJA DE PETRI, DE LA WEB DEFINICION.DE
Julius Richard Petri fue un científico alemán nacido el 31 de mayo de 1852 en Barmen, un distrito perteneciente a la ciudad de Wuppertal, y fallecido el 20 de diciembre de 1921 en Zeitz. Especializado en microbiología, se trata del inventor de un recipiente para el cultivo de células.
La caja de Petri, también conocida como placa de Petri, fue ideada por este microbiólogo cuando colaboraba con Robert Koch (1843-1910), el médico que recibió el Premio Nobel de Literatura en 1905. Petri ideó el recipiente en 1877.
La caja de Petri tiene forma redonda y dispone de una tapa con un diámetro mayor que el recipiente en sí mismo. Esto permite que la caja se cierre pero de no manera hermética. En la caja de Petri es posible desarrollar el cultivo de células.
Es habitual que las cajas de Petri sean utilizadas en laboratorios para el cultivo de microorganismos. Por lo general el fondo del recipiente se cubre con un medio de cultivo y luego se trabaja con la proliferación de las bacterias u organismos en cuestión.
Además de todo lo expuesto, es necesario conocer otros aspectos relevantes sobre la mencionada caja de Petri entre los que podemos destacar los siguientes:
• -Además de para cultivar células, se utiliza para observar el comportamiento de algunos animales de pequeño tamaño e incluso para proceder a germinar semillas. De la misma manera, también se emplea para masar sólidos.
• -El descubrimiento y creación de la caja de Petri se convirtió de forma inmediata en un verdadera revolución. Desde entonces hasta ahora ha jugado un papel esencial en la historia pues, entre otras cosas, ha servido para proceder a aislar organismos relacionados con enfermedades como el cólera o la difteria.
• -Las personas que trabajan con este tipo de dispositivo y de organismo que guarda en su interior es esencial que lleven a cabo las mayores medidas de seguridad y precaución. Sí, porque es la manera de no verse infectados, por ejemplo.
• -Algunos modelos de esta citada caja presentan ranuras o detalles en relieve. El objetivo de estos es que cuando son guardadas no puedan escurrirse de la superficie en la que se encuentran.
• -Suelen tener unos 10 centímetros de diámetro y suelen fabricarse con dos materiales, sobre todo. Nos estamos refiriendo tanto al vidrio como al plástico. Las ventajas que tienen las de vidrio es que se pueden reutilizar. Eso sí, para volver a emplearse es necesario que se las someta a una esterilización y a una descontaminación haciendo uso de un horno a una temperatura aproximada de 160º.
Existen distintas técnicas para el uso de la caja de Petri. Si se desean estudiar colonias de microorganismos, el recipiente puede colocarse boca abajo para que el medio de cultivo quede en el sector superior. Cuando el vapor de agua provocado por el metabolismo de los organismos se condensa, cae en la tapa, mientras que los seres se mantienen adheridos al sustrato.
-------------------------------------------
📣Conoce mucho más de La Voz Silenciosa©:
👉 Creepypastas: bit.ly/2OMAz5C
🔎 Definiciones: bit.ly/2Lo0MoW
📜 ¿Te gustan los Poemas?: bit.ly/2YlZbFx
📝 Relatos o historias cortas: bit.ly/2YhkpVd
Donar: paypal.me/DIAZSALADO
#LaVozSilenciosa #Definiciones #Etimología
información de la web definicion.de
Caja de Petri de vidrio 100X15 mm - Laboratorios Wacol S.A. Nuevo

Imágenes Caja Petri de vidrio 100x20mm. Modelo 1177-10 – Científica Vela Quin S Último

Fotos Caja de Petri de Pared Reforzada 100x20 mm | Mellth viral

Cajas Petri Vidrio Esterilizable De 100x15mm ( Paq. 22 Pz.) | Mercado Libre viral

Caja petri de vidrio 100x15 mm pieza - Grupo JAFS actualizar

Asunto CAJAS PETRI EN VIDRIO NORMAX | Norquimicos Ltda | Equipos para Laboratorio volviéndose viral

Caja Petri plastica desechable 100 X 20 mm Nest actualizar

Ver Cajas Petri: Caja Petri vidrio 20 cms. tendencias

Ver Caja Petri De Vidrio 100x20mm Uso Laboratorio | MercadoLibre Último

Ver Caja de Petri estéril de 35mm, PK/20 - Tienda ARBiotech tendencias

Ver Caja Petri Vmlab Plástico Estéril 60x15 Desechables 50 Pzas | Mercado Libre actualizar

Asunto Caja Petri, Estéril, Desechable, 90x15 Triple (y) - $ 3,528.00 en actualizado